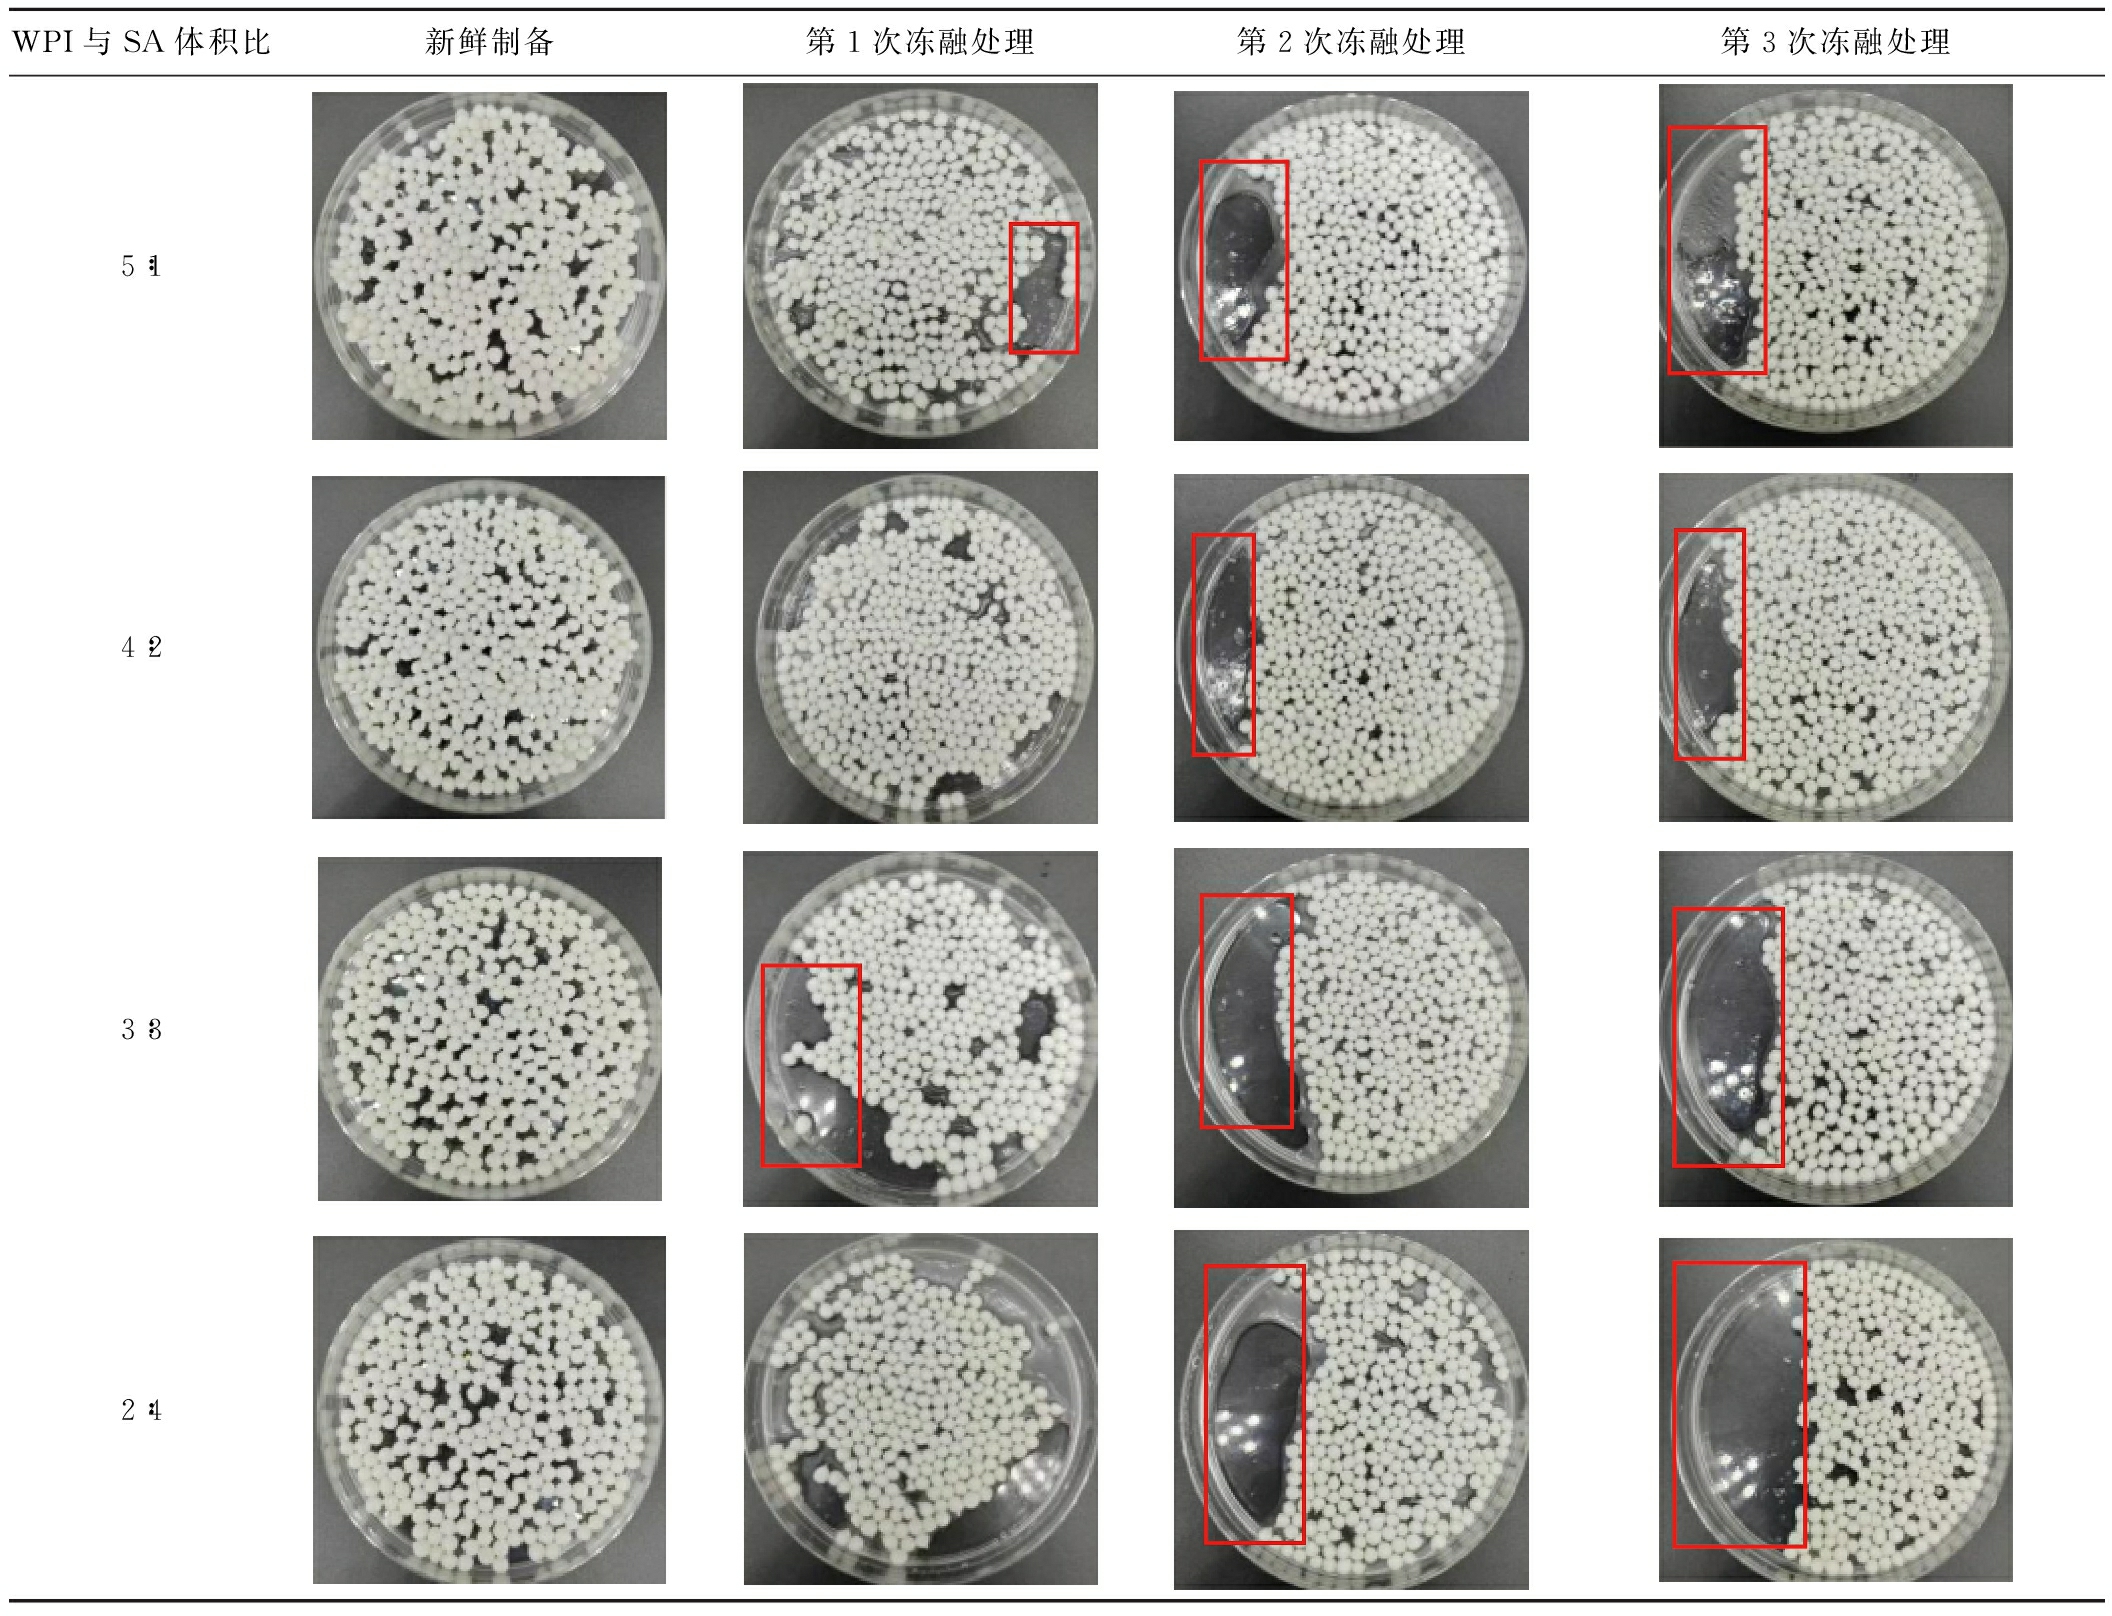

紫苏籽油是由紫苏的种子压榨和精炼而来,为淡黄色透明油状液体,营养丰富。紫苏籽油富含不饱和脂肪酸,例如α-亚麻酸、亚油酸、花生四烯酸、多酚、γ-生育酚、黄酮和植物甾醇等[1]。其中α-亚麻酸含量是已知天然植物油中含量最高的,占50%~70%[2]。α-亚麻酸是体内一种必需脂肪酸[3],但在体内无法合成,经脱氢和碳链延长在体内转化成二十碳五烯酸(eicosapentaenoic acid,EPA)和二十二碳六烯酸(docosahexaenoic acid,DHA)[4]。DHA是构成大脑脑磷脂及神经细胞膜磷脂的重要成分,也是促进和维持神经系统细胞生长的主要成分[5]。有研究发现,以食用紫苏油替换豆油后,20名位老年人血浆中DHA、EPA含量有所提高,这证明了紫苏籽油可防治心脑血管疾病[6-7]。紫苏籽油可以通过改善肠道菌群结构达到减少肥胖小鼠脂肪积累,调节脂肪代谢水平,提高超氧化物歧化酶(superoxide dismutase,SOD)在大鼠脑组织中的活性以及血清中谷胱甘肽过氧化物酶(glutathione peroxidase,GSH-Px)的活性,抗氧化[8-9]、降血脂等目的[10-14]。
然而,庞晓慧等[3]研究发现紫苏籽油相较于美藤果油以及亚麻籽油具有更高含量的α-亚麻酸,但紫苏籽油的氧化速率、维生素E和多酚等营养物质的损失率是最高的,氧化稳定性最差。紫苏籽油中α-亚麻酸等不饱和脂肪酸极易受到外界环境因素的影响,在加工和贮存过程中易发生氧化变质,生成醛酮酸等物质从而严重限制了紫苏籽油产品的开发[15]。现有研究中,多集中于利用复配乳化剂将紫苏籽油制成乳剂、喷雾制粒以微胶囊和软胶囊等方式来克服紫苏籽油易氧化的缺点[16],在酸性和高温等食品环境应用场景有限。
乳液凝胶是一种将油滴填充在凝胶网络结构中的软固体体系[17]。乳液凝胶连续相中紧凑的三维网络结构可以抵御破坏活性物质的光热环境,为系统中包裹的敏感活性物提供良好的保护[18-19]。乳液凝胶制备材料中,蛋白质和多糖基的乳液凝胶因为具有优异的生物相容性而备受关注,但是蛋白基乳液凝胶需要通过高温加热、强酸强碱等剧烈的交联方式制备,不利于包封对这些条件敏感的活性物质[20]。海藻酸钠(sodium alginate,SA)是从褐藻类的海带或马尾藻中获得的一种天然多糖类材料,具有无毒、易凝胶成型、抗氧化、抑菌和保鲜的特点[21]。其分子由β-D-甘露糖醛酸(β-D-mannuronic,M)以及α-L-古洛糖醛酸(α-L-guluronic,G)通过1-4糖苷键连接而成[22]。海藻酸钠分子中含有大量的羧基,当向海藻酸钠的水溶液中添加二价阳离子(如Ca2+)时,海藻酸钠G单元的Na+会与这些二价阳离子发生交换、折叠并积累,然后拉伸的分子链转变为有序的带结构,最终形成一个具有三维分子网络的“蛋盒”模型凝胶[23]。在食品行业中利用其凝胶特性通过不同方式制备成球,可以形成作为输送载体的微米到毫米级的微胶囊,从而保护内容物活性[24-26]。张志慧等[27]以火麻仁分离蛋白以及黄原胶复合物为原料制备乳液凝胶包封亚麻籽油,制备的乳液凝胶具有良好的支撑性能,能够明显减缓亚麻籽油贮藏期间氧化产物生成速率。
截止目前,关于乳液凝胶系统在包封紫苏籽油以达到减缓氧化速率的应用研究尚未得到充分验证。因此本研究选择乳清分离蛋白(whey protein isolate,WPI)作为乳化剂,SA作为乳液凝胶壁材,制备紫苏籽油乳液凝胶,以期抵抗酸性食品应用环境、冷热交替等不良贮藏条件带来的负面影响,拓宽紫苏籽油的应用场景。
1 材料与方法
1.1 材料与试剂
WPI粉(纯度:90%),新西兰恒天然公司;无水氯化钙、SA,上海源叶生物科技有限公司;紫苏籽油,河北家丰植物油有限公司;氯仿、氯化亚铁、三氟乙酸、硫氰酸铵(分析纯),西陇化工股份有限公司。
1.2 仪器与设备
XHF-DY高速均质机,信智生物技术有限公司;HL-2B数显恒流泵,上海沪西分析仪器厂有限公司;LNMI 20-15低场核磁共振仪,纽迈电子科技(苏州)有限公司;906GPULTS真空冷冻干燥机,赛默飞尔上海有限公司;TA-XT Plus质构分析仪,英国Stable Micro System公司;CiX62型色度仪,美国爱色丽公司;Mastersizer 3000激光粒度仪、Nano ZS90纳米粒度及Zeta电位分析仪,英国马尔文公司;PH-05A电热恒温干燥箱,上海一恒科学仪器有限公司;SDT Model Q600热重分析仪,美国TA Instrument公司。
1.3 实验方法
1.3.1 乳液凝胶球的制备
配制20 g/L SA溶液,400 r/min搅拌24 h充分溶解,置于4 ℃冷藏备用。配制80 g/L的WPI,室温下搅拌2 h,置于4 ℃下冷藏过夜,以保证WPI充分水合。然后在85 ℃条件下加热30 min使蛋白质完全变性,冷却至室温备用。将WPI溶液与SA溶液以体积比(下同)为5∶1、4∶2、3∶3、2∶4、1∶5、0∶6的比例混合,再加入紫苏籽油,使得最终所有样品体系中紫苏籽油含量占比均为20%。以13 000 r/min的速度高速均质3 min获得乳液体系,将乳液通过恒流泵匀速滴入20 g/L CaCl2溶液中,室温下静置30 min,形成均匀大小的乳液凝胶球。
1.3.2 成球乳液的粒径及Zata电位测定
将制备好的乳液体系分散到去离子水中,使用蒸馏水将所有储备溶液稀释至500×,在常温条件下采用纳米粒度及Zeta电位分析仪测定蛋白和多糖颗粒的表面Zata电位。参考DU等[28]的方法,通过使用激光粒度仪测量用于制备球粒的所有乳液室温(25 ℃)下的粒径尺寸分布。水和紫苏籽油的折射率分别为1.33和1.47,根据尺寸分布测量值结果,将平均乳滴尺寸报告作为体积平均直径D(4,3)。
1.3.3 乳液凝胶球的表征
通过使用测微卡尺测量40个单个球的直径。使用手持式精密色差仪测定WPI-SA乳液凝胶球的色度。室温下对色差仪进行校准,取适量测试样品紧密铺平,将色差仪的测试口与被测样品紧密贴合,保持稳定并且不漏光,测定并记录样品亮度值L*、红绿值a*、黄蓝值b*。样品白度W计算如公式(1)所示:
(1)
1.3.4 乳液凝胶球质构特性测定
将新鲜制备的WPI-SA乳液凝胶球(约2 g)以直径50%压缩置于探针下的固定底板上。实验前、实验和实验后的速度分别设定为1.0、0.5、1 mm/s。此外,触发力为1 g,2次加载之间的时间为5 s。采用Texture Expert 1.22版软件计算乳液凝胶球珠的硬度、内聚性、弹性、胶黏性和咀嚼性等质构参数。
1.3.5 乳液凝胶球的持水性测定
参照ZHANG等[30]的方法,取WPI-SA乳液凝胶球(约5 g)样品置于离心管中,离心管质量为M1(g),称量WPI-SA乳液凝胶球与离心管总质量为M2(g),随后,在8 000 r/min离心10 min后将析出的水分倒出,用滤纸擦干离心后WPI-SA乳液凝胶球表面的水分,称量离心后WPI-SA乳液凝胶球质量记为 M3(g),重复操作3次,取平均值。持水性(water-holding capacity,WHC)计算如公式(2)所示:
(2)
1.3.6 乳液凝胶球的低场核磁共振(low-field nuclear magnetic resonance,LF-NMR)水分分布
参考WANG等[31]的方法稍作修改,将WPI-SA乳液凝胶球样品置于直径为25 mm的核磁共振试管中,测定横向弛豫时间(T2)。实验参数如下:CPMG脉冲序列,共振频率21 MHz,连续扫描间隔时间6 500 ms,回波时间0.7 ms,回波次数18 000,扫描次数4。利用Multi Exp Inv Analysis软件对LF-NMR弛豫曲线进行多指数曲线拟合,得到各峰位T2和峰面积比例。
1.3.7 乳液凝胶球的傅里叶红外光谱(Fourier transform infrared spectrometer,FTIR)测定
经冷冻干燥处理后的WPI与SA体积比为3∶3的乳液凝胶球以及直接取用WPI和SA粉末,使用红外光谱仪对待检测样品进行红外扫描。取样品粉2 mg 与KBr粉末198 mg置于玛瑙研钵中研磨成粉末状态,压片机压片。扫描范围4 000~400 cm-1, 分辨率4 cm-1。扫描次数32次。
1.3.8 乳液凝胶球微观结构观察
将新鲜制备的WPI-SA乳液凝胶球置于去离子水中溶胀15 min,再把WPI-SA乳液凝胶珠表面水分擦干,置于液氮中速冻,并在真空冷冻干燥机内冻干。将冻干球用小刀垂直于桌面切开,保持切面平滑,用离子溅射仪喷金后再用扫描电镜进行观察,放大倍数为100倍。
1.3.9 乳液凝胶球冻融稳定性测定
参照黄子璇等[32]的方法,将制得的WPI-SA乳液凝胶球于-80 ℃冷冻4 h,恢复至室温后,再次置于-80 ℃冷冻4 h,该冷冻-融化循环共重复操作3次,每次WPI-SA乳液凝胶球恢复值至室温后进行质构特性测定与外观拍摄,质构特性测定方法参照1.3.4节。
1.3.10 乳液凝胶球的热稳定性测定
通过使用热重分析仪测量现制WPI-SA乳液凝胶球的热稳定性。将样品置于铂盘上,将温度从30 ℃升至600 ℃,以10 ℃/min的速率扫描加热温度,监测时间和温度方面的质量损失。
1.3.11 乳液凝胶球的贮藏稳定性测定
参照LIANG等[33]的方法对乳液凝胶的贮藏稳定性进行测定。取100 g乳液凝胶球置于玻璃管中,60 ℃烘箱中贮藏7 d,取样测定贮藏0、3、5、7 d的脂肪的过氧化值(peroxide value,POV)、硫代巴比妥酸反应物(thiobarbituric acid reactive substance,TBARS)含量。
1.3.11.1 POV测定
根据LIANG等[33]的方法稍作修改。将2 gWPI-SA乳液凝胶球捣碎后与1.5 mL的异辛烷-异丙醇(3∶1,体积比)混合,涡旋振荡10 s后离心5 min,取上清液200 μL和2.8 mL甲醇-正丁醇(2∶1,体积比)于离心管中,然后依次加入15 μL 3.94 mol/L KSCN和15 μL Fe2+溶液,涡旋振荡10 s后在室温环境下静置20 min,在510 nm处测定样品吸光度。以过氧化氢异丙苯为标准品制定标准曲线。POV计算如公式(3)所示:
(3)
式中:A510,510 nm吸光值;M,Fe2+的标准曲线斜率;m0,比色时相当样品质量,g。
1.3.11.2 TBARS的测定
参照GB 5009.181—2016《食品国家安全标准 食品中丙二醛的测定》。
1.3.12 乳液凝胶球的环境稳定性测定
取WPI与SA体积比为4∶2、3∶3、2∶4的现制乳液凝胶球(每种配料比取20个)置于小玻璃瓶中,向其中分别加入10 mL不同 pH(1.5、4.5和7.5)的水溶液,涡旋混合1 min,于室温下贮藏7 d后观察乳液凝胶表观状态并拍照记录。
1.4 数据处理
所有测试至少进行3次,数据表示为“平均值±标准差”。基于单因素方差分析(ANOVA),使用IBM SPSS Statistics 21.0版软件(IBM Corp,Armonk,NY,USA)进行差异显著性分析。统计学意义显著性水平P<0.05。所有数据图形均使用Origin2021C 64位软件创建。
2 结果与分析
2.1 成球乳液的粒径分布及Zeta电位
Zeta电位决定了生物聚合物之间静电相互作用的性质,因此测试了用于制备乳液凝胶球的WPI-SA复合物乳液的电特性。SA是一种聚阴离子电解质,包含不同SA含量的所有乳液均具有高度负电荷。如图1所示,当SA含量增加时,溶解暴露出带负电的羧基使得溶液具有更负的表面电位。乳滴之间的静电排斥力增强,可以防止乳滴发生聚集等失稳现象,乳液稳定性得到提高[34]。

图1 用于制备乳液凝胶球的WPI-SA复合物乳液的Zeta电位
Fig.1 The Zeta-potential of a WPI-SA complex emulsion for the preparation of emulsion gel spheres
注:不同小写字母表示差异显著(P<0.05)(下同)。
如图2所示,所有乳液的粒径均呈现多峰分布,说明所有乳液的分散不均一。当WPI与SA体积比为3∶3和2∶4时,分布峰值粒径的尺寸最小,这可能是由于SA的羧基与WPI的氨基酸发生静电排斥,不易发生团聚,从而导致粒径尺寸变小。而仅由SA构成的紫苏籽油乳液分布峰值粒径尺寸较大,不利于乳液稳定。平均粒径减小可缩短油滴间的距离,使油滴间相互作用增加,从而增加乳液的稳定性。这表明适量添加SA和WPI对紫苏籽油的乳化具有促进作用。其中WPI主要发挥油-水界面的表面活性剂作用,而SA主要发挥提高乳液稳定性的作用。由表1可知,WPI与SA体积比为3∶3和2∶4的平均体积直径D(4,3)较小,同样印证了该2种复合乳液具有更高的乳液稳定性。

图2 用于制备乳液凝胶球的WPI-SA复合物乳液的粒径分布图
Fig.2 Size distribution of WPI-SA complex emulsion for preparation of emulsion gel spheres
表1 用于制备乳液凝胶球的WPI-SA复合物乳液的粒径尺寸
Table 1 The particle size of the WPI-SA complex emulsion for the preparation of emulsion gel spheres

WPI与SA体积比D(4,3)/μm5∶1274.69±2.68b4∶2125.11±4.99c3∶385.90±2.15e2∶467.02±2.75f1∶5108.80±2.79d0∶6289.11±2.37a
注:不同小写字母表示差异显著(P<0.05)(下同)。
2.2 乳液凝胶球的形貌
将WPI-SA复合物乳液与Ca2+交联制备成WPI-SA乳液凝胶球的外观图如图3所示。WPI与SA体积比为1∶5和0∶6的乳液凝胶球有轻微的拖尾现象,呈现出水滴状。其余乳液凝胶球均为圆球状。这是由于SA添加量的提高使得乳液体系黏稠度增加。在挤出过程中WPI-SA复合物乳液附着在恒流泵的胶管上,挤出的乳滴坠入CaCl2溶液过程中变形,滴入CaCl2溶液后瞬间成型,使得凝胶球呈现水滴状。在CaCl2溶液中静置30 min时,Ca2+不断向凝胶球内部渗入,最终形成类似果冻状、质地柔软、有弹性的乳液凝胶球。由表2可知,所有乳液凝胶球球粒的直径分布为(3.63±0.22)~(6.11±0.55) mm,并且SA含量的占比越高,直径越大。

图3 WPI-SA乳液凝胶球外观图
Fig.3 The appearance of WPI-SA emulsion gel spheres
注:图中比例为WPI与SA的体积比(下同)。
表2 WPI-SA乳液凝胶球球粒直径
Table 2 Diameters of WPI-SA emulsion gel spheres

WPI与SA体积比球粒直径/mm5∶13.63±0.22c4∶24.20±0.20b3∶34.35±0.33b2∶44.38±0.44b1∶54.42±0.17b0∶66.11±0.55a
2.3 乳液凝胶球的色度分析
不同体积比的WPI-SA乳液凝胶球色度测定结果见表3,L*和a*值差异性显著(P<0.05),b*值无明显差异。仅由SA构成的乳液凝胶球L*值最小,亮度最小,透明度更高。WPI与SA体积比为4∶2和3∶3的乳液凝胶球L*值最高。SA和WPI体积比接近3∶3时亮度最高,并且增大了黄色度和绿色度。结合表3以及乳液凝胶球宏观图可以得出,所有WPI-SA乳液凝胶球呈白色偏淡黄绿。
表3 WPI-SA乳液凝胶球L*、a*、b*和W值
Table 3 The L*, a*, b* and W of WPI-SA emulsion gel spheres

WPI与SA体积比L*值a*值b*值W值5∶174.58±1.43d-0.44±0.02b11.93±0.06b28.10±1.28b4∶282.36±2.64a-0.80±0.02d12.63±0.72a21.72±2.56d3∶381.15±1.39ab-0.78±0.04d12.11±0.28ab22.42±1.27cd2∶479.15±1.79bc-0.55±0.05c11.48±0.09b23.82±1.61cd1∶577.73±0.92c-0.40±0.03b11.43±0.42b25.04±0.90c0∶665.21±0.33e-0.20±0.05a11.43±0.13b36.62±0.28a
2.4 乳液凝胶球的质构分析
不同SA含量的WPI-SA乳液凝胶球在质构特性上存在显著差异。为探究该体系乳液凝胶球是否符合感官需求,测定了WPI-SA乳液凝胶球的质构。硬度被认为是达到一定变形所需的力,它可以作为食品硬度的量度。如图4所示,随着SA含量的增加,WPI-SA乳液凝胶球的硬度不断增强,单独由SA构成的乳液凝胶球硬度最高。所以WPI-SA乳液凝胶球主要由SA与Ca2+形成的“蛋壳”网络状结构所构成[23]。SA含量越高,形成的网络结构越坚固,越不易发生变形。但是添加过多的SA导致WPI-SA乳液凝胶球的弹性下降,这表明添加适量的WPI可以改善WPI-SA乳液凝胶球的弹性。凝胶珠应具有较高的硬度和弹性,以便这些含有活性化合物的胶囊可以应用于功能性食品中[35]。综合分析,WPI和SA体积比为3∶3、2∶4和1∶5的WPI-SA乳液凝胶球具有较高的弹性和硬度,符合功能性食品应用条件。

a-硬度;b-弹性;c-内聚力;d-咀嚼性和胶黏性
图4 WPI-SA乳液凝胶球的质构特性
Fig.4 Texture characteristics of WPI-SA emulsion gel spheres
硬度是咀嚼性的基础,硬度高的食品通常需要更大的咀嚼力。内聚力是指被测食品在破裂时所能产生的一种力,反映了材料在咀嚼过程中保持完整性的能力[36],内聚力是咀嚼性的重要组成部分,高内聚力的食品在咀嚼过程中不易破碎,需要更多的咀嚼次数。咀嚼性是将固体食物咀嚼到准备吞咽的状态所需的能量,反映了凝胶的机械性能,并为咀嚼凝胶时的主观感官评价提供参考[37]。高SA含量的WPI-SA乳液凝胶珠的胶黏性和咀嚼性均显著高于低含量SA WPI-SA乳液凝胶珠的胶黏性和咀嚼性。当海藻酸钠添加量低于WPI时,内聚力与SA添加量呈正相关。SA含量不低于WPI含量时,内聚力与SA含量无显著性关系。
2.5 乳液凝胶球的WHC分析
持水性大小可以反映WPI-SA乳液凝胶球的稳定性和强度[38]。由图5可知,所有的WPI-SA乳液凝胶球WHC均超过80%,说明该体系的WPI-SA乳液凝胶球网络结构可以有效封锁内部水分。并且SA的占比越高,WPI-SA乳液凝胶球WHC越强。仅由SA构成的凝胶球最高。这表明SA浓度越高的WPI-SA乳液凝胶球对离心力的抵抗力越强,可能是由于随着SA浓度的增加,SA分子与Ca2+交联度越高,形成的“蛋壳”状网络结构越坚固[23],从而稳定内部空间结构,提高了WHC。

图5 WPI-SA乳液凝胶球WHC
Fig.5 WHC of WPI-SA emulsion gel spheres
2.6 乳液凝胶球的LF-NMR水分分布分析
LF-NMR通常用于测定凝胶系统中水分子的迁移率和比例,各组分的T2可以用来确定凝胶对水的结合能力。凝胶系统中的水根据T2范围可分为3种状态[39]:结合水(T21:0~10 ms)、不易流动水(T22:10~100 ms)和自由水(T23:100~1 000 ms)。T2缩短说明水分流动性减弱,而T2延长反映水分流动性的增强。由图6-a和6-c可以看出所有配料比的WPI-SA乳液凝胶球中主要由不易流动水构成,含有微量的结合水,几乎没有自由水,这意味着水的流动性减弱,说明该凝胶体系可以有效固定水分,这与WHC的结论一致。

a-整体T2水分分布图;b-局部放大T21(结合水)水分分布;c-峰面积比例图
图6 不同配料比对WPI-SA乳液凝胶球的弛豫时间(T2)分布和峰面积比例的影响
Fig.6 Effects of different ratio of ingredients on relaxation time (T2) distribution and peak area ratio of WPI-SA emulsion gel spheres
2.7 乳液凝胶球FTIR分析
将冷冻干燥后的WPI与SA体积比为3∶3的WPI-SA乳液凝胶球、WPI和SA进行FTIR分析,以揭示乳液凝胶化学结构是否发生变化[40]。如图7所示,游离SA在1 636 cm-1处的特征吸收峰为C![]() O的伸缩振动[41];WPI在1 636 cm-1处的特征吸收峰为C
O的伸缩振动[41];WPI在1 636 cm-1处的特征吸收峰为C![]() O伸缩振动峰[42]。形成复合物后,波数没有发生明显偏移,说明WPI与SA产生了物理相互作用,即静电斥力。WPI-SA乳液凝胶球的红外光谱中并没有出现新的吸附峰,表明在凝胶制备过程中没有发生化学反应。
O伸缩振动峰[42]。形成复合物后,波数没有发生明显偏移,说明WPI与SA产生了物理相互作用,即静电斥力。WPI-SA乳液凝胶球的红外光谱中并没有出现新的吸附峰,表明在凝胶制备过程中没有发生化学反应。

图7 WPI与SA体积比为3∶3的WPI-SA乳液凝胶球、WPI和SA的FTIR
Fig.7 FTIR of WPI-SA emulsion gel spheres with ratio of 3∶3, WPI, and SA
2.8 乳液凝胶球的扫描电镜图分析
凝胶网络的微观结构与凝胶的性质密切相关。由图8可以看出,所有样品均具有不同大小程度的空腔,并且随着SA含量的增加,空腔越来越小。WPI与SA体积比为5∶1时形成的凝胶结构非常粗糙松散,并且呈现蛋白质团聚状。脂质颗粒受到的限制减弱,脂质颗粒容易移动而重新聚集以变大尺寸,导致该体积比下形成的凝胶较弱。随着SA的加入,乳液凝胶球的结构更加致密,空隙更小,并且具有更光滑的表面和更致密的三维网络结构。仅由SA形成的凝胶则有较大的空隙,脂质颗粒之间也容易重新聚集变大,这与质构的结果相一致。

图8 WPI-SA乳液凝胶球的扫描电镜图(100×)
Fig.8 Scanning electron microscope images of WPI-SA emulsion gel spheres(100×)
2.9 乳液凝胶球的冻融稳定性分析
不同WPI与SA体积比形成的WPI-SA乳液凝胶球在-20 ℃时冻融循环 1~3 次的外观如表4所示。经过第1次冻融循环,WPI-SA乳液凝胶球均出现水分析出。并且每次冻融处理后,将相同凝胶球颗粒数铺平平板后出现了不同程度的空白面积,这说明粒径发生收缩。但是没有油相析出的现象。经过第2、3次冻融循环后,水分析出更加明显,WPI-SA乳液凝胶球总体积也明显缩减,依旧没有油相析出,说明该乳液凝胶体系封锁油相效果明显。
表4 WPI-SA乳液凝胶球冻融后的外观图
Table 4 The apperance of freeze-thaw WPI-SA emulsion gel spheres
WPI与SA体积比新鲜制备第1次冻融处理第2次冻融处理第3次冻融处理5∶14∶23∶32∶4
续表4

WPI与SA体积比新鲜制备第1次冻融处理第2次冻融处理第3次冻融处理1∶50∶6
表5为不同体积比的WPI-SA乳液凝胶经过冻融循环后的硬度指标,所有WPI-SA乳液凝胶球经过冻融循环后硬度值均增加。这是因为经过冷冻-解冻过程后,乳液凝胶球的内部三维网络结构在冰晶形成和融化的循环中被破坏,导致乳液凝胶质构和内部水分分布发生变化,从而使得水分合并析出。综合表4和表5可知,该体系的WPI-SA乳液凝胶球经过冻融循环后虽然硬度有所上升,但是依旧能够封锁油相。
表5 WPI-SA乳液凝胶球冻融后的硬度
Table 5 The hardness of freeze-thaw WPI-SA emulsion gel spheres

冻融处理WPI与SA体积比5∶14∶23∶32∶41∶50∶6冻融处理前68.00±2.65c194.33±5.24d337.33±5.55d428.33±2.96d566.00±7.23bc686.67±6.23a第1次冻融循环163.67±3.18b346.67±4.06c393.33±5.36c404.00±5.29c548.33±3.18c740.33±3.53b第2次冻融循环169.33±5.21b393.67±6.12b453.67±5.21b643.00±4.73b587.00±11.37b841.00±6.35c第3次冻融循环200.67±4.91a444.33±7.13a486.67±5.55a667.00±4.26a635.33±2.96a917.67±7.31d
2.10 乳液凝胶球的热稳定性分析
热重分析是研究物质的质量与温度之间的关系的技术,可以用于考察物质热力学性能。不同WPI-SA乳液凝胶球热重变化趋势见图9。WPI与SA体积比为4∶2、3∶3、2∶4的乳液凝胶球热重曲线走势相似。在 300~500 ℃,WPI-SA乳液凝胶球的质量百分比减少明显加快, 而在500~600 ℃则趋势减缓。在300~500 ℃对应于乳液凝胶球中存在组分的化学分解。

图9 WPI-SA乳液凝胶球的热重
Fig.9 Thermogravimetric diagram of WPI-SA emulsion gel spheres
WPI与SA体积比为5∶1和0∶6的乳液凝胶球则显示2次质量减轻。第一次在50~100 ℃范围内,该温度区间对应于乳液凝胶球结构的水分损失。在300~500 ℃,同样存在质量百分比明显快速减少的现象,对应于乳液凝胶球中存在组分的化学分解。
该结果可以显示当WPI与SA体积比为4∶2、3∶3、2∶4 的乳液凝胶球显示出较好的热稳定性,相较于WPI与SA体积比为5∶1和0∶6的乳液凝胶球可以有效提升抵抗100 ℃左右的高温水分流失的效果。
2.11 乳液凝胶的贮藏稳定性
贮藏过程中初级氧化产物和次级氧化产物的变化可反映WPI-SA乳液凝胶球中脂质的氧化速率。POV 用于测量初级氧化产物(氢过氧化物)的形成,而 TBARS 用于测量次级分解产物[丙二醛(malondialdehyde acid,MDA)]的形成。以紫苏籽油组作为对照,乳液凝胶贮藏稳定性结果见图10。随着贮藏时间的延长,所有样品中的POV和MDA明显增加。与紫苏籽油相比,WPI-SA乳液凝胶球均表现出明显的脂质氧化抑制作用。当WPI与SA体积比为1∶1时,脂质氧化速率最低,贮藏期间产生POV、MDA的速率最慢,乳液凝胶的抗氧化性最强。这是由于当WPI与SA体积比为1∶1时,所形成的乳液凝胶液滴尺寸更小、分布更加均匀,增强了凝胶网状结构,形成致密的界面层,可以阻碍油滴与连续相中促氧化剂如金属离子之间的接触[43],并且阻止氧自由基的传递和转移,进而明显减缓了乳液凝胶贮藏过程中初级氧化产物、次级氧化产物的产生速率。

a-POV;b-MDA含量
图10 WPI-SA乳液凝胶球的贮藏稳定性
Fig.10 Storage stability of WPI-SA emulsion gel spheres
2.12 乳液凝胶球的应用环境稳定性
选择凝胶网络结构较强,并且有显著抵抗高温水分流失以及降低油脂氧化速率作用的乳液凝胶球(WPI与SA体积比为4∶2、3∶3、2∶4),在不同pH水溶液中放置7 d后外观如图11所示。由图11可以看出,pH值为1.5和4.5时乳液凝胶球在贮藏期间均保持稳定,没有发生油相析出现象。这是因为在酸的作用下填充在油滴间的SA所带电荷迅速由负电转为正电,与乳化油滴表面的WPI产生静电引力从而吸附在油滴表面,继续稳定了油滴,提高了乳液凝胶球的稳定性[44]。在pH值为7.5的溶液中有少量油相析出,但是乳液凝胶球结构仍未有明显破损现象。说明成功构建的该凝胶体系的凝胶网络结构可以抵抗不良酸性环境的破坏,有利于乳液凝胶球在酸性环境中的应用与贮藏。

A-WPI与SA体积比为4∶2;B-WPI与SA体积比为3∶3;C-WPI与SA体积比为2∶4
图11 WPI-SA乳液凝胶球在pH=1.5、4.5、7.5的溶液中贮藏 7 d 后的外观图
Fig.11 The appearance of the emulsion gel spheres after storage in pH=1.5、4.5 and 7.5 solution for 7 days
3 结论
本研究构建了WPI-SA乳液凝胶球系统,通过测定构成WPI-SA乳液凝胶球的复合乳液的Zeta电位和粒径,发现当WPI与SA体积比为3∶3[(85.90±2.15) μm]和2∶4[(67.02±2.75) μm]的体积平均直径D(4,3)较小,而未添加WPI[(289.11±2.37) μm]和SA添加量最少[(274.69±2.68) μm]的乳液D(4,3)较大。粒径的减小不仅影响乳液的稳定性,还增强了凝胶网状结构,形成致密的孔隙结构,进一步提升乳液凝胶球的抗氧化性能。WPI与SA体积比为3∶3的乳液凝胶球使紫苏籽油贮藏7 d的POV由(36.25±0.93) mmol/kg减小至(24.41±0.80) mmol/kg。
通过利用扫描电镜、LF-NMR和质构仪研究了不同体积比对WPI-SA乳液凝胶球物理性质的影响,证实了SA含量对乳液凝胶珠的质构、网状结构和水分分布特征具有显著影响。综合考量发现,WPI与SA体积比为3∶3的乳液凝胶球的弹性、硬度、胶黏性、持水性以及三维网络结构表现最优,并且可以提高抗100 ℃左右的水分流失能力。经过冻融循环测试后,所有乳液凝胶球抗水分析出能力较弱,但能够保留油相。筛选出的WPI与SA体积比为4∶2、3∶3、2∶4的乳液凝胶球在酸性环境溶液中贮藏7 d后未有结构破损和油相析出的现象。
本研究为乳液凝胶体系在功能性油脂封装和保护中的应用提供了重要的理论依据,可以用于开发营养强化食品,如富含多不饱和脂肪酸的乳制品、饮料和烘焙食品等。但其在抗氧化、胃肠中的释放特性等方面的功能仍需进一步验证,未来研究可聚焦于其抗氧化作用的分子机制,系统评估乳液凝胶体系对紫苏籽油抗氧化性能的提升效果。探索其在胃肠道中的释放特性,研究其作为靶向递送系统的可能性,以提高功能性成分在特定部位的吸收和利用效率。
[1] 王荣,王娜娜,杨宽,等. 紫苏籽油的抗衰老作用及机制探究[J].中国油脂, 2025 ,50 (6):101-104;110.WANG R,WANG N N,YANG K,et al. Study on anti-aging effect and mechanism of perilla seed oil[J].China Oil and Fats, 2025 ,50 (6):101-104;110.
[2] 谭善财,邬小兰,黄珍,等. 梵净山不同叶型的紫苏籽油的提取及其脂肪酸组成分析[J].粮食与油脂,2021,34(11):67-71;93.TAN S C,WU X L,HUANG Z, et al. Extraction and analysis composition of fatty acid of perilla seed oil of different leaf types from Fanjingshan[J].Cereals &Oils, 2021,34(11):67-71;93.
[3] 庞晓慧,李俊健,吴俏槿,等.美藤果油、亚麻籽油和紫苏籽油氧化稳定性对比研究[J].中国油脂,2021,46(1):32-37.PANG X H,LI J J,WU Q J, et al. Comparative study on oxidation stability of sacha inchi oil, flaxseed oil an perilla seed oil[J].Cereals &Oils,2021,46(1):32-37.
[4] 王亚,范玲玲,马挺军.超声辅助β-环糊精包合法提取紫苏籽油α-亚麻酸工艺研究[J].中国粮油学报,2021,36(12):78-83.WANG Y,FAN L L, Ma T J.et al Comparative study on oxidation stability of perilla seed oil extracted by ultrasonic-assisted β-cyclodextrin encapsulation[J].Journal of the Chinese Cereals and Oils Association,2021,36(12):78-83.
[5] 何雅雯,李孟俊,于修烛,等.不同食用油氧化稳定性比较研究[J].中国油脂,2018,43(3):44-49.HE Y W, LI M J,YU X Z, et al. Comparative study on oxidation stability of different edible oils[J].China Oil and Fats,2018,43(3):44-49.
[6] 王锋.不同来源ω-3多不饱和脂肪酸对2型糖尿病合并血脂异常人群糖脂代谢的影响及机制研究[D].南京:东南大学.2017.WANG F. Effects and mechanisms of different soures of ω-3 polyunsaturated fatty acids on glucose and lipid metabolism in type 2 diabetes patients with dyslipidemia[D].Nanjing: Southeast University,2017.
[7] 郭晨阳, 白明, 苗明三. 果类中药资源的综合利用[J].中医学报,2019,34(4):742-744.GUO C Y,BAI M,MIAO M S. Comprehensive utilization of fruit TCM resources[J].Chinese Medicine and Natural Products,2019,34(4):742-744.
[8] 张瑜,戚欣,白艺珍,等.紫苏籽油化学组成与检测技术研究进展[J].食品安全质量检测学报, 2020,11(20):7181-7188.ZHANG Y,QI X,BAI Y Z,et al.Advances in chemical composition and related detection technologies of perilla seed oil[J]. Journal of Food Safety &Quality,2020,11(20):7181-7188.
[9] 吴娆,马飞,张良晓,等.高效液相色谱-串联质谱法测定紫苏籽油中11种酚类化合物[J].分析化学,2015,43(10):1600-1606. WU Y, MA F, ZHANG L X, et al. Simultaneous determination of 11 phenolic compounds in Perilla oil by high performance liquid chromatography tandem mass spectrometry[J].Analytical Chemistry,22015,43(10):1600-1606.
[10] 贾佼佼, 李艳, 苗明三. 紫苏的化学、药理及应用[J].中医学报,2016,31(9):1354-1356.JIA J J,LI Y,MIAO M S. Chemistry, pharmacology and application analysis of perilla frutescens[J].Chinese Medicine and Natural Products,2016,31(9):1354-1356.
[11] KAMALASHIRAN C, SRIYAKUL K, PATTARAARCHACHAI J, et al. Outcomes of perilla seed oil as an additional neuroprotective therapy in patients with mild to moderate dementia: A randomized control trial[J]. Current Alzheimer Research, 2019, 16(2):146-155.
[12] WANG F, ZHU H J, HU M Y, et al. Perilla oil supplementation improves hypertriglyceridemia and gut dysbiosis in diabetic KKAy mice[J]. Molecular Nutrition &Food Research, 2018, 62(24):1800299.
[13] MIN Y, DJAHANBAKHCH O, HUTCHINSON J, et al. Efficacy of docosahexaenoic acid-enriched formula to enhance maternal and fetal blood docosahexaenoic acid levels: Randomized double-blinded placebo-controlled trial of pregnant women with gestational diabetes mellitus[J]. Clinical Nutrition, 2016, 35(3):608-614.
[14] 陈雪梅,胡博,唐晓姝,等.紫苏籽油对小鼠肠道微生物及抗氧化能力的影响[J].食品与发酵工业,2024,50(16):271-277.CHEN X M,HU B,TANG X S, et al. Effects of perilla seed oil on intestinal microorganisms and antioxidant capacity in mice[J].Food and Fermentation Industries,2024,50(16):271-277.
[15] LIANG L, LEUNG SOK LINE V, REMONDETTO G E, et al. In vitro release of α-tocopherol from emulsion-loaded β-lactoglobulin gels[J]. International Dairy Journal, 2010, 20(3):176-181.
[16] 梁旭,王宪龄,陈德壮,等.紫苏籽油的研究和应用现状[J].中医学报,2022,37(3):547-551.LIANG X,WANG X L,CHEN D S,et al. The research and application atatus of perilla seed oil[J]. Chinese Medicine and Natural Products, 2022,37(3):547-551.
[17] 李松南.淀粉基Pickering乳液稳定机理及在叶黄素递送中的应用研究[D].广州:华南理工大学,2020.LI S N. Tarch-based pickering emulsion: Stabilizing mechanism and application in lutein delivery[D]. Guangzhou: South China University of Technology,2020.
[18] TANG Z Q, HE H C, ZHU L, et al. A general protein unfolding-chemical coupling strategy for pure protein hydrogels with mechanically strong and multifunctional properties[J]. Advanced Science, 2022, 9(5):2102557.
[19] MURAB S, GUPTA A, W ODARCZYK-BIEGUN M K, et al. Alginate based hydrogel inks for 3D bioprinting of engineered orthopedic tissues[J]. Carbohydrate Polymers, 2022, 296:119964.
ODARCZYK-BIEGUN M K, et al. Alginate based hydrogel inks for 3D bioprinting of engineered orthopedic tissues[J]. Carbohydrate Polymers, 2022, 296:119964.
[20] ENSANDOOST R, IZADI-VASAFI H, ADELNIA H. Anti-bacterial activity of chitosan-alginate-poly (vinyl alcohol) hydrogel containing entrapped peppermint essential oil[J]. Journal of Macromolecular Science, Part B, 2022, 61(2):225-237.
[21] HE X D, ZENG L Y, CHENG X P, et al. Shape memory composite hydrogel based on sodium alginate dual crosslinked network with carboxymethyl cellulose[J]. European Polymer Journal, 2021, 156:110592.
[22] MOSTAGHIMI M, MAJDINASAB M, HOSSEINI S M H. Characterization of alginate hydrogel beads loaded with thyme and clove essential oils nanoemulsions[J]. Journal of Polymers and the Environment, 2022, 30(4):1647-1661.
[23] GÜNTER E A, MARKOV P A, MELEKHIN A K, et al. Preparation and release characteristics of mesalazine loaded calcium pectin-silica gel beads based on callus cultures pectins for colon-targeted drug delivery[J]. International Journal of Biological Macromolecules, 2018, 120:2225-2233.
[24] DENG X L, CHEN J H, CHEN W. Hydrogel particles as a controlled release delivery system for lavender essential oil using pH triggers[J]. Colloids and Surfaces A: Physicochemical and Engineering Aspects, 2020, 603:125134.
[25] XU P X, SONG J F, DAI Z Q, et al. Effect of Ca2+ cross-linking on the properties and structure of lutein-loaded sodium alginate hydrogels[J]. International Journal of Biological Macromolecules, 2021, 193:53-63.
[26] 张勉羚,肖建辉,孙超,等.甘薯蛋白水解物对钙离子诱导下海藻酸钠凝胶形成的影响[J].食品科学技术学报.2023,41(4):67-81.ZHANG M L,XIAO J H,SUN C,et al Effects of sweet potato protein hydrolysates on formation of calcium ion-induced sodium alginate gel[J].Food Journal of Food Science and Technology,2023,41(4):67-81.
[27] 张志慧,李雨凝,张光耀,等.不同质量比的火麻仁分离蛋白与黄原胶复合物对乳液凝胶稳定性的影响[J].食品研究与开发.2023,44(17):1-7.ZHANG Z H,LI Y N,ZHANG G Y,et al. Effects of different mass ratios of hemp seed protein isolate and xanthan gum complex on emulsion gel stability[J]. Food Research and Development.2023,44(17):1-7.
[28] DU X Q, HU M, LIU G N, et al. Development and evaluation of delivery systems for quercetin: A comparative study between coarse emulsion, nano-emulsion, high internal phase emulsion, and emulsion gel[J]. Journal of Food Engineering, 2022, 314:110784.
[29] 李可,孙立雪,周彦芳,等.超声波处理对类 PSE 鸡肉肌浆蛋白与肌原纤维蛋白复合凝胶特性的影响[J].食品科学,2024,45(22):189-198.LI K,SUN L X,ZHOU Y F,et al.Effect of utrasonic treatment on the properties of PSE-like chicken sarcoplasmic protein and myofibrillar protein composite gels[J].Food Science,2024,45(22):189-198.
[30] ZHANG C, LIM S T. Physical modification of various starches by partial gelatinization and freeze-thawing with xanthan gum[J]. Food Hydrocolloids, 2021, 111:106210.
[31] WANG H L, RAO P F, XIE Z D, et al. Exploring the interaction between Lycium barbarum polysaccharide and gelatin: Insights into gelation behaviors, water mobility, and structural changes[J]. Food Hydrocolloids, 2024, 148:109415.
[32] 黄子璇, 林伟锋. 酸性热致大豆分离蛋白聚集体制备高冻融稳定性类蛋黄酱乳液[J].现代食品科技,2020,36(10):218-225;92.HHUANG Z X,LIN W F.Mayonnaise-like emulsions with high freeze-thaw stability prepared by acid-heat-induced soy protein isolate aggregates[J].Modern Food Science and Technology,2020,36(10):218-225;92.
[33] LIANG L, CHEN F, WANG X G, et al. Physical and oxidative stability of flaxseed oil-in-water emulsions fabricated from sunflower lecithins: Impact of blending lecithins with different phospholipid profiles[J]. Journal of Agricultural and Food Chemistry, 2017, 65(23):4755-4765.
[34] 李杨,徐清清,韩璐,等.添加菊粉条件下的豌豆分离蛋白乳化特性研究[J].农业机械学报,2020,51(7):382-388.LI Y, XU Q Q, HAN L, et al. Emulsifying properties of pea protein isolate with inulin[J].Transactions of the Chinese Society for Agricultural Machinery,2020,51(7):382-388.
[35] ![]() S, et al. Improving the controlled delivery formulations of caffeine in alginate hydrogel beads combined with pectin, carrageenan, chitosan and Psyllium[J]. Food Chemistry, 2015, 167:378-386.
S, et al. Improving the controlled delivery formulations of caffeine in alginate hydrogel beads combined with pectin, carrageenan, chitosan and Psyllium[J]. Food Chemistry, 2015, 167:378-386.
[36] SHANG L C, WU C L, WANG S S, et al. The influence of amylose and amylopectin on water retention capacity and texture properties of frozen-thawed konjac glucomannan gel[J]. Food Hydrocolloids, 2021, 113:106521.
[37] MUDGIL D, BARAK S, KHATKAR B S. Texture profile analysis of yogurt as influenced by partially hydrolyzed guar gum and process variables[J]. Journal of Food Science and Technology, 2017, 54(12):3810-3817.
[38] 梁秀萍.乳清分离蛋白-海藻酸钠乳液递送体系的设计及其对番茄红素稳态化的机制研究[D].杨凌:西北农林科技大学,2021.LIANG X P. Design of whey protein isolate-sodium alginate emulsion delivery systems and their stabilization mechanism of lycopene[D].Yangling: College of Food Science and Engineering Northwest A&F University,2021.
[39] ZHUANG X B, HAN M Y, BAI Y, et al. Insight into the mechanism of myofibrillar protein gel improved by insoluble dietary fiber[J]. Food Hydrocolloids, 2018, 74:219-226.
[40] GUO C, LI X F, GONG T, et al. Gelation of Nicandra physalodes (Linn.) Gaertn. polysaccharide induced by calcium hydroxide: A novel potential pectin source[J]. Food Hydrocolloids, 2021, 118:106756.
[41] KARKEH-ABADI F, SABER-SAMANDARI S, SABER-SAMANDARI S. The impact of functionalized CNT in the network of sodium alginate-based nanocomposite beads on the removal of Co(Ⅱ) ions from aqueous solutions[J]. Journal of Hazardous Materials, 2016, 312:224-233.
[42] YU J, WANG G R, WANG X B, et al. Improving the freeze-thaw stability of soy protein emulsions via combing limited hydrolysis and Maillard-induced glycation[J]. LWT, 2018, 91:63-69.
[43] YI J, GAN C, WEN Z, et al. Development of pea protein and high methoxyl pectin colloidal particles stabilized high internal phase Pickering emulsions for β-carotene protection and delivery[J]. Food Hydrocolloids, 2021, 113:106497.
[44] 乔蕾蕾,杨敏,秦娟娟,等.酸诱导酪蛋白胶束-海藻酸钠乳液凝胶性质及其对原花青素的负载性能研究[J].食品科学,2023,44(16):50-60.QIAO L L,YANG M,QIN J J, et al. Properties and proanthocyanidin-loading capacity of acid-induced micellar casein-sodium alginate emulsion gels[J].Food Science,2023,44(16):50-60.